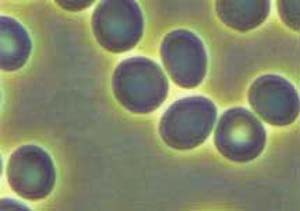
Live Blood Analysis picture

Parasites as seen in live blood analysis
We are on week 9 of the latest live blood analysis online training course and now studying dry blood analysis. We are now looking at dry blood under the microscope with a higher magnification. This is where we can see signs of parasites - what we actually see is the toxins that parasites leave behind. [...]